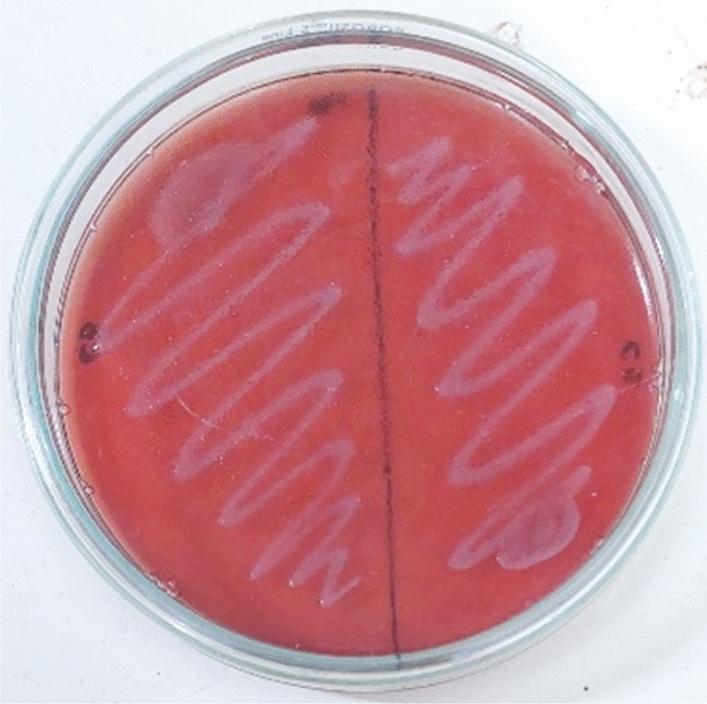
https://cdn.ncbi.nlm.nih.gov/pmc/blobs/a3de/11227525/02c55501ceea/41598_2024_66597_Fig9_HTML.jpg

从重要草药“九里香”中分离出的乳球菌的益生菌评估、黏附能力和安全性评价。
Probiotic evaluation, adherence capability and safety assessment of Lactococcus lactis strain isolated from an important herb "Murraya koenigii".
机构信息
School of Biosciences and Technology, Vellore Institute of Technology, Vellore, 632014, India.
出版信息
Sci Rep. 2024 Jul 6;14(1):15565. doi: 10.1038/s41598-024-66597-7.
Lactic acid bacteria (LAB) isolated from medicinal herb Murraya koenigii, commonly known as curry leaf, which promotes the growth and maintenance of gut microbiota, were studied for their probiotic potential. The key objective of this research was to isolate and evaluate probiotic characteristics, test adherence capabilities, and confirm their safety. Lactococcus lactis (MKL8), isolated from Murraya koenigii, was subjected to in vitro analysis to assess its resistance to the gastric environment, ability to adhere Caco-2 cells, anti-microbial activity, hydrophobicity, auto-aggregation, and safety profiling through MTT assay and hemolytic. MKL8 exhibited growth at 0.5% phenol concentrations (> 80%) and was able to survive in conditions with high bile concentrations (> 79%) and a relatively low pH (72%-91%). It shows high tolerance to high osmotic conditions (> 73%) and simulated gastric juice (> 72%). Additionally, MKL8 demonstrated strong hydrophobicity (85%), auto-aggregation (87.3%-91.7%), and adherence to Caco-2 cells. Moreover, it had an inhibitory effect against pathogens too. By performing the hemolytic and MTT assays, the non-toxicity of MKL8 isolate was examined, and it exhibited no harmful characteristics. Considering MKL8's resistance to gastrointestinal tract conditions, high surface hydrophobicity, non-toxicity, and ability to inhibit the tested pathogens, it can be concluded that MKL8 demonstrated promising probiotic properties and has potential for use in the food industry.
从药用植物咖喱叶(俗称咖喱叶)中分离出的乳酸杆菌(LAB),可以促进肠道微生物群的生长和维持,对其益生菌潜力进行了研究。本研究的主要目的是分离和评估益生菌特性、测试黏附能力,并确认其安全性。从咖喱叶中分离出的乳球菌(MKL8)进行了体外分析,以评估其对胃环境的抵抗力、黏附 Caco-2 细胞的能力、抗微生物活性、疏水性、自动聚集性以及通过 MTT 测定和溶血试验进行的安全性分析。MKL8 在 0.5%苯酚浓度(>80%)下生长良好,能够在高胆汁浓度(>79%)和相对低 pH(72%-91%)条件下生存。它对高渗透压条件(>73%)和模拟胃液(>72%)具有很强的耐受性。此外,MKL8 表现出很强的疏水性(85%)、自动聚集性(87.3%-91.7%)和对 Caco-2 细胞的黏附能力。此外,它还对病原体具有抑制作用。通过进行溶血和 MTT 试验,检查了 MKL8 分离株的非毒性,结果表明它没有毒性特征。考虑到 MKL8 对胃肠道条件的抵抗力、高表面疏水性、非毒性和抑制测试病原体的能力,可以得出结论,MKL8 表现出有希望的益生菌特性,并且具有在食品工业中应用的潜力。